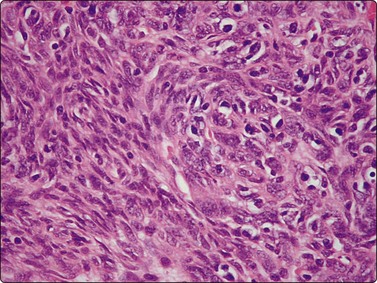
image

CHAPTER 9 Mediastinum
Clinical aspects
A broad range of mass lesions is found in this site, of which about 40% are malignant. Two major factors in the incidence of different entities are the age of the patient at presentation and the mediastinal compartment in which the mass arose and appears radiographically. Tumors in children are more likely to be neurogenic neoplasms, enterogenous cysts, teratomas, vascular lesions or lymphomas. In adults, the most common mass lesions are metastases and cysts of thymic, pericardial or enteric origin, followed by thymomas, neurogenic tumors, lymphomas and germ cell tumors.1-3
Lesions of the anterior/superior mediastinum are more likely to be thymic epithelial neoplasms, thymic cysts, lymphoma, thyroid and parathyroid proliferations and germ cell tumors. Of those in the middle mediastinum, lymphoma and pericardial or bronchogenic cysts predominate. Masses in the posterior mediastinum consist mostly of nerve sheath or neuronal tumors and bronchogenic or enteric cysts.1-3
Clinical and laboratory findings may be helpful. For example, such clues include the presence of high levels of circulating human chorionic gonadotrophin (beta-hCG) and alpha-fetoprotein in certain germ cell tumors, myasthenia gravis (although recall that myasthenia is more commonly associated with follicular hyperplasia of the thymus), red cell aplasia, hypogammaglobulinemia in thymoma, and Cushing’s syndrome in carcinoids.1-3
The mediastinum is a common site for metastases, especially from the lung, and these are far more frequent than primary malignancies. Accordingly, the specific diagnosis of primary thymic carcinoma, neuroendocrine carcinomas and germ cell neoplasms can only be made after exclusion of tumors derived from other sites.
Most lesions are illustrated in other chapters.
The place of FNAC in the investigative sequence
Fine needle aspiration has long been used for the confirmation of metastatic disease and is increasingly accepted as the basis for the management of primary mediastinal malignancies. After imaging, FNB is generally the first-line diagnostic method, although some suggest that core biopsy gives higher rates of specific tumor typing for lymphoma, thymoma and neural tumors (at the cost of lower sensitivity).4,5 Mediastinoscopy and open thoracotomy and biopsy are still necessary for some primary lesions, particularly Hodgkin lymphoma, rare lesions such as sarcoma where architectural features may be necessary for a fully specific diagnosis or where the initial material is insufficient for immunochemistry, ultrastructure, cytogenetics or molecular analysis, although all of these techniques may be applied to material obtained by FNB. Endoscopic ultrasound (EUS) guided FNB via the transoesophageal or transbronchial routes has become an indispensable method of identifying lymph node metastases in lung cancer diagnosis and staging, and in mediastinal lesions out of the reach of transbronchial or transtracheal sampling.6-10 Occasionally we have experienced difficulty in verifying the exact site of origin of malignant cells in such specimens as a result of contamination of the sample by malignancy derived from the primary tumor in bronchus or esophagus,11 despite the use of stilettes. This may limit the use of the technique for staging in some cases. However, one good rule of thumb is that a true metastasis is supported when one microscopically witnesses an intimate admixture of malignant cells and reactive lymphoid elements, especially germinal center fragments.
The selection of cases for EUS-FNB has been the subject of recent study. Eltoum et al. suggest that careful evaluation of pre-test probability of malignancy may help in deciding which patients are likely to benefit from EUS-FNB.12
Mediastinal infections are amenable to diagnosis by FNB,13 as is sarcoidosis.14
Accuracy of diagnosis
Most cancers will be diagnosed as malignant, and accurate tumor typing is often possible.15-37 For example, a diagnosis of a specific germ cell tumor can be achieved with clinical data and conventional cytomorphology supplemented with a small panel of antibodies.25,36 For example, whereas germinomas yield a highly characteristic cytologic picture, embryonal and endodermal sinus carcinomas are less specific-appearing.
Thymic epithelial neoplasms may prove very challenging, especially when the tumor is lymphocyte rich. The admixture of cytologically bland epithelial cells and reactive lymphoid cells is typical of the mixed thymomas. With pure epithelial tumors, the recognition of relatively benign nuclei in epithelial-appearing cells and the high smear cellularity in the proper clinical context is often sufficient, especially if supported by the results of ancillary testing. Lymphocyte-rich tumors may prove quite challenging, as discussed later. The distinction of benign and invasive thymomas cannot be made on cytomorphology alone. What the radiologist and especially the surgeon have to say is crucial. Thymic carcinomas are rare, have the features of obvious epithelial malignancy, and require accurate clinical data, often aided by the addition of certain ancillary procedures.
It is often difficult to obtain material from sclerotic lesions such as nodular sclerosing Hodgkin lymphoma by fine needle alone, but a combination of cytology and cell blocks or thin core sampling can give diagnostic material.37 For the non-Hodgkin lymphomas, a specific diagnosis is possible for many lymphomas using a combination of cytomorphology, immunophenotyping by either flow cytometry or immunochemistry on cytospins, cell blocks or thin cores, and at times genetic and cytogenetic tests.38
Powers et al.25 reported a large multi-institutional study of 189 FNA cases with a sensitivity of 87% and a positive predictive value of 97% for a diagnosis of neoplasm. Metastatic small cell carcinoma was the commonest neoplasm, followed by lymphoma and thymoma as the commonest primary tumors. Singh et al.39 reviewed material from the same institutions, looking specifically at diagnostic pitfalls including 12 cases with discordant cytology and follow-up histology. These included small cell carcinoma resembling lymphoma, Hodgkin lymphoma and large cell lymphoma with prominent spindle cell components suggesting a connective tissue neoplasm, large cell lymphoma diagnosed as Hodgkin lymphoma, thymoma resembling large cell lymphoma, clear cell adenocarcinoma where the possibility of germ cell tumor was raised, thymic carcinoma with insufficient tissue to distinguish from benign thymoma, ectopic thyroid resembling metastatic carcinoma or carcinoid, and a breast carcinoma with a squamous appearance. Sparse cellularity was a contributing factor in most cases and the recommendation for biopsy for definitive typing was often made. Assaad et al. reviewed the results of 157 CT-FNB and were able to make definitive diagnoses in 82% of cases with a high concordance with subsequent histological diagnoses.40 Geisinger reviewed the range of pitfalls and problems which may be found in cytodiagnosis in this site.41
Khan et al. showed 66% sensitivity in the diagnosis of tuberculosis compared with 20% for fibreoptic bronchoscopy.13
Complications
The complications of aspiration of this site are no more frequent than in FNA of the lung. Even when superior vena caval obstruction is present, aspiration appears to be very safe, and is the procedure of choice.16,17,22,24 CT has particular value in this site, as it can localize the needle tip within the lesion far better than fluoroscopy,16,17 and thus rare complications such as cardiac tamponade can be avoided. Prior CT scanning is used to exclude aneurysm and delineate relationships with adjacent structures, including large vessels. Endoscopic ultrasound (EUS) guided FNA by the transoesophageal and transbronchial routes has further reduced the risk of bleeding or other complications.7 Nevertheless, as with all deep aspirates, there may be complications. Von Bartheid et al. documented a mediastinal-oesophageal fistula after FNB of TB.42 Aerts et al. reported a case of mediastinitis after puncture of a necrotic metastatic malignancy in a node.43 Doi et al. describe needle track tumor implantation in the oesophageal wall after EUS. The clinical background of each case must be considered before embarking on the procedure.44
Technical considerations
Obtaining material
Direct FNB is carried out using fluoroscopic, ultrasound45 or CT guidance, including transthoracic46 and suprasternal47 approaches. Transbronchial or transcarinal FNB is especially useful in diagnosing and staging metastatic disease, but may also reveal primary lesions.7-9,47-50 Endoscopic ultrasound guided FNB has rapidly become an essential tool in the staging of lung carcinomas because of the precision with which needles can be directed into nodal metastases.7-9 It may be used by transoesophageal or transbronchial routes.7-9 Mediastinal cystography yields a strong guide to the nature of cysts.51 Fibrosis and non-specific chronic inflammation sometimes prevent adequate sampling and even mediastinoscopy may not be successful. However, we have found FNA samples to be better than core biopsies on numerous occasions and believe this should be the first-line method, with supplemental material for other tests being based on initial cytological assessment. The thin needle may track into cellular areas better than cores and samples material over a wider area. With the pathologist at the procedure, FNB and core biopsy become complementary. One can evaluate touch preparations of cores at the time of procurement to assess their adequacy, and even assist in diagnosis.
Ancillary testing (Table 9.1)
Our approach to diagnosis is similar to that in other deep sites. The pathologist is present at the aspirate with a microscope to confirm adequacy of material and to prepare for appropriate ancillary studies. We rely particularly on cell-block preparations and immunocytochemistry due to the extraordinary variability of neoplasms of this site; cytological features alone are often not sufficient for the specific diagnosis of some primary tumors. Either repeated aspiration passes or core biopsy using automatic sampling devices is a very useful way of obtaining additional material for ancillary tests and/or for architectural analysis. Neill and Silverman52 and Taccagni et al.53 emphasized the value of ultrastructural diagnosis, particularly for thymoma, germ cell tumors, carcinoid tumors and small cell carcinoma. However, today EM is being supplanted by immunophenotyping due to the expense of EM, the greater sampling error with EM, and the much greater availability of immunochemistry. For example, Akhtar et al.36,54 and Singh et al.39 see immunocytochemistry as necessary for confirmation of germ cell tumor type. Immunocytochemistry or flow cytometry are routinely used for diagnosis and typing of non-Hodgkin lymphomas (see Chapter 5). Powers et al. used ancillary tests in 27% of their cases.25,39 Herman et al. noted lower sensitivity and ability to type tumors accurately in the period before the use of ancillary tests.23
Table 9.1 General outline of ancillary tests in the differential diagnosis of mediastinal tumours1-376

It was hoped that molecular analysis may help pinpoint the site of origin in patients with tumors of unknown origin,55-57 although recent applications of molecular analysis have turned to its use in targeted drug therapy rather than specific tumor typing.
Cytological findings
The mediastinum is a common site of metastasis for neoplasms from all sites. In FNA samples, small cell carcinoma of lung is the most frequent metastasis, with lesser numbers of non-small cell tumors of lung, followed by breast carcinoma.25 Metastatic sarcomas may also be seen, but remember the possibility of origin from a germ cell tumor if a malignant spindle cell neoplasm is encountered. Rare primary sarcomas may also be seen.
Baker et al.58 suggested that in sampling mediastinal nodes by the transbronchial route, lymphocytes are necessary to confirm specimen adequacy, otherwise bronchial contents may be misinterpreted as originating from mediastinum. As stated above, we agree.
Thymoma (Figs 9.1-9.6)18,25-35,59-63




Fig. 9.1 Thymoma, lymphoepithelial
(A) Cohesive fragments of tumor tissue in a background of lymphoid cells (Pap, LP); (B) Cohesive cluster. Epithelial cells visible centrally Pap HP; (C) Cell block, indistinct epithelial cells (H&E, HP); (D) Cell block, reticular pattern of epithelial cell staining for AE1+3 keratins (IPOX, LP).


Fig. 9.2 Thymoma, lymphoepithelial
(A) Less cohesive pattern with loose groups of epithelial cells (Pap, IP); (B) Loose group of epithelial cells with pale chromatin and conspicuous nucleoli (Pap, HP).

Fig. 9.4 Thymoma, lymphoepithelial; metastatic within lung
Biphasic cell population of lymphocytes and epithelial cells with pale nuclei, small nucleoli and indistinct cytoplasm; note the Hassall’s corpuscle (Pap, HP oil).

Fig. 9.5 Thymoma, spindle cell
Cohesive tissue fragment; elongated pale, regular nuclei; indistinct cell borders (H&E, HP oil).
Criteria for diagnosis
The histologic classification of thymomas is complex, evolving, and still somewhat controversial. Such subclassification may prove challenging for the histopathologist and this is exaggerated with aspiration cytology. Clearly, there is a wide spectrum in the cytomorphology of thymomas. First, there is a broad range of appearances of benign thymoma cells among and even within some of these neoplasms; this is complicated by the varying proportions of lymphocyes present.
In the benign thymomas, the epithelial cells are usually cohesive (Figs 9.1, 9.5) but may also manifest a reduction in intercellular cohesion (Fig. 9.2). Epithelial cells are not immediately evident in the mixed tumors at low power but are discernible using the higher magnification.18,29,30 The epithelial cells are polygonal, oval, or spindle shaped with uniform to slightly irregular nuclear outlines possibly with cleaved or folded nuclei. Their nuclear chromatin is homogeneous, finely distributed and pale and, occasionally, small nucleoli are seen. Cell borders are indistinct, but nuclei are separated by moderate amounts of pale cytoplasm (Figs 9.2, 9.5). In one personally examined case of thymoma metastatic to lung, Hassall’s corpuscles were evident in the clumps of tumor cells (Fig. 9.4); this is a most unusual manifestation and will not be present in most thymomas. When there is a lymphoid population, the bimodal pattern enables one to make a virtually certain diagnosis.18,29,30 In pure epithelial or spindle cell forms, definitive diagnosis is more difficult, although in Dahlgren’s series29 most thymomas were diagnosed and in Tao’s 37 cases30 all FNAC diagnoses of thymoma were verified histologically. Ali and Erozan34 were able to diagnose all of their 14 cases using a combination of cytology, immunocytochemistry and clinical information, and Shin and Katz showed a high accuracy in a range of mediastinal lesions including 14 thymomas.35 Tao and others describe more variation in the degree of cohesion than we have seen, particularly in pure epithelial/nonspindle cell types.30 Overall, the most challenging and the most common in our experience are the lymphocyte-rich (type B1) thymomas, as the tumor cells may be obscured by the lymphocytes.
Large cell lymphoma with sclerosis may yield cohesive fragments of tissue, resembling lymphocyte-rich thymomas. Immunophenotyping for lymphoma and ultrastructural or immunoperoxidase demonstration of an epithelial component in thymoma will help resolve the differential diagnosis. The clinical background may be misleading, as in a case of malignant thymoma in an HIV-positive patient.64 Lymphoma cells compressed within collagen may resemble a spindle cell neoplasm.
Type B1 thymomas contain lymphoid cells of immature thymic type. These may be selectively sampled and give a false impression of lymphoma, especially lymphoblastic lymphoma. Similarly, if material is submitted for flow cytometry, the immature T phenotype may cause confusion. However, a maturing T-cell phenotype is characteristic of thymoma and thus is quite helpful in this situation. The immature cells demonstrate CD1, 2, 4, 5, 7 and 8 positivity and TdT, representing the common or intermediate stage of thymocyte differentiation, a profile similar to that of T-lymphoblastic lymphoma.65 Some cases also demonstrate apparent ‘loss’ of various T-cell markers, heightening a suspicion of T-cell lymphoma. In our experience, unless the cytologist reviewing material either in the radiology theatre or in the lab alerts the haematology laboratory to the likelihood of lymphocyte-rich thymoma, there is a very real risk of false-positive diagnosis of lymphoblastic lymphoma by flow cytometry.
Other spindle cell lesions within the mediastinum include benign and malignant connective tissue neoplasms, reactive processes with or without associated neoplasms, granulomas, mesothelioma, melanoma, spindle cell squamous carcinoma and spindle cell carcinoid.66,67 Connective tissue neoplasms may be cohesive but, especially in neural tumors, have a more abundant and more myxoid stroma than thymomas. Spindle cell squamous carcinoma shows cytological features of malignancy lacking in thymoma; however, primary spindle squamous carcinoma of the thymus (a form of thymic carcinoma) is described. An approach which includes ancillary testing in all cases will help prevent error.
A specific diagnosis of invasive thymoma can only be achieved by histological assessment or in concert with clinical/surgical findings.
Sometimes, non-neoplastic thymic epithelium may be included in an FNB sample and give rise to erroneous tumor typing. Yu et al.45 described a case of large cell lymphoma in which this occurred and then demonstrated entrapped thymic epithelium in a third of their cases of surgically excised large cell lymphomas. There was reactive proliferation of the epithelium in some cases. Thymic hyperplasia may completely mimic thymoma in smears.68,69
The monolayered presentation of mesothelium with intercellular windows allows this to be distinguished from thymic epithelium or neoplastic tissue.
Malignant thymoma (Figs 9.2, 9.7 and 9.8)1-3,18,25,64,70-74
Thymic carcinomas are very uncommon cytologically malignant tumors with a wide variety of morphological appearances including keratinizing and nonkeratinizing squamous, sarcomatoid, anaplastic large cell, basaloid, mucoepidermoid, clear cell and small cell types.1-3 A cytological diagnosis of carcinoma may be made by FNB. Smears are variably cellular and usually dominated by loosely cohesive large malignant cells diagnostic of carcinoma. Most are composed of large tumor cells with solitary clearly malignant nuclei, with or without prominent nucleoli. As expected, their smear appearance resembles the underlying histopathology. Reports of FNB diagnosis of rare subtypes such as basaloid and mucoepidermoid carcinomas area also reported.73,74



(A) Disorganized aggregate of pleomorphic malignant cells with macronucleoli; (B) Cell block showing poorly differentiated large cell carcinoma; (C) Staining of tumor cells for CD5 (A, Pap, HP; B, Cell block. H&E, HP; C, cell block, IPOX).

Borderline nuclear criteria of malignancy. Poorly cohesive cells with fragile cytoplasm, rounded or ovoid nuclei, bland chromatin and small but prominent nucleoli; note the mitosis (Pap, HP).
Anaplastic carcinoma from other sites is not distinguishable from primary thymic carcinoma on cytomorphology alone. Dorfman et al.75 found CD5 positivity in tumor cells to be characteristic of primary carcinomas, in contradistinction to benign thymomas and carcinomas from other sites. Newer markers such as Foxn1 and CD205 may also prove useful.76
The distinction between thymic carcinoma and invasive thymoma is based on cytological characteristics of malignancy in the former.
A histogenetic classification of thymomas has been accepted by some (see above).1-3 The older classification (spindle, lymphocytic, epithelial and mixed) and the newer subgrouping (medullary, mixed, predominantly cortical (organoid), cortical and well-differentiated thymic carcinoma) both have prognostic relevance.2,3,77 The subtypes in these two systems can be related histologically2,3 although cytological findings alone may not allow accurate prediction of tumor type. Some authors still advocate a simple morphological classification into thymoma, atypical thymoma and thymic carcinoma.78 All authors acknowledge that staging is a crucial aspect of assessment of biological behavior.1-378 Shimosato et al. trace the conceptual evolution of thymoma and thymic carcinoma classification and staging.1
Neuroendocrine neoplasms66,79-86 (see also Chapter 8)
Primary neuroendocrine tumors of the mediastinum include carcinomas ranging from low to high grade (carcinoid, atypical carcinoid, large cell carcinoma, and small cell carcinoma).1-3 Cytomorphologic criteria for diagnosis are quite similar to those in other sites, especially the lung. Although there is a spectrum of biologic behavior correlating with grade, even apparently low-grade neoplasms may show very aggressive clinical behavior in the mediastinum.83-85 Furthermore, tumors with combined low-grade and high-grade morphologic attributes occur with some relative frequency.84 The low-grade ones may also produce paraneoplastic syndromes, especially Cushing’s syndrome. When combined with the characteristic radiologic finding of focal calcifications, this may suggest the diagnosis prebiopsy. These tumors are associated with multiple endocrine neoplasm syndromes in about 25% of cases, usually type 1.87 Gherardi describeed intracytoplasmic paranuclear keratin inclusions similar to those seen in Merkel cell tumors, small cell carcinoma and other neuroendocrine neoplasms in three cases sampled by FNB.79 These structures were best demonstrated in Romanowsky stains as optically clear paranuclear spaces, confirmed by cytokeratin staining in smears, along with Grimelius staining, NSE positivity and Leu-7 or chromogranin staining in several cases. Paranuclear apoptotic material was also observed in some cells and there was discohesion, mitotic activity, single cell necrosis and tingible body macrophages in the background, producing a resemblance to lymphoma. Lymphoglandular bodies were not seen. Wang et al. diagnosed four cases of thymic carcinoid tumor without atypical features.80 They found Riu’s stain or argyrophilia useful for identifying neurosecretory granules in the cytoplasm. One patient had Cushing’s syndrome and the tumor cells demonstrated ACTH positivity. In Dusenbury’s case, the diagnosis was made by cytology and positive synaptophysin staining.66 A spindle cell component was described. Smith et al. diagnosed an unusual lipid-rich carcinoid tumor by FNA.86
Neural neoplasms (see Chapter 15)
Most mediastinal neural tumors arise in the posterior compartment. Neurofibromas, schwannomas and ganglioneuromas occur mainly in adults and are often detected as asymptomatic masses by X-ray, or by pain or other symptoms of local pressure. In the paediatric population, neuroblastoma and ganglioneuroblastoma predominate here. Aspiration may be difficult because of the cohesiveness of tissue, and more vigorous needling and/or core biopsies may be necessary. The cytological findings are described in detail in Chapter 15. In the mediastinum the differential diagnosis includes spindle cell thymoma, carcinoid, other connective tissue neoplasms, lymphoma with associated sclerosis and reactive connective lesions.67 Cell blocks and immunocytochemistry or electron microscopy are valuable. Diagnosis of malignancy and specific typing of primary malignant nerve sheath tumors is extremely difficult, if not impossible, on aspirated material. Caution should be applied, as some benign lesions are extremely pleomorphic and cellular; mitotic activity and necrosis are more useful criteria in raising the suspicion of malignancy. If a cell block with ample tumor is available, then S-100 protein immunostaining may help. With benign nerve sheath tumors, staining is diffuse and intense, whereas their malignant counterparts manifest rather weak, focal decoration or are totally negative.
Dahl et al.,88 Dahlgren and Ovenfors89 and Zbieranowski and Bedard90 described series of schwannomas in FNAC. Palombini and Vetrani outlined the FNAC findings in mediastinal ganglioneuroma and ganglioneuroblastoma.91,92 In one case there was a mixture of polyhedral cells including binucleate forms with abundant eosinophilic cytoplasm and smaller oval or spindle cells. The findings suggested ganglioneuroblastoma; elevated VMA levels in serum helped to confirm the diagnosis. In others, a fibrillar background in MGG preparations was a diagnostic clue suggesting neuritic processes.
Pure neuroblastomas occur mainly in children and present as small round cell tumors, with a background neuropil.93,94 Calcifications are common. They are further described in Chapter 17.
Paragangliomas may arise in the mediastinum.95 Smears are usually highly cellular, but the major tumor cell contour is variable, not only from neoplasm to neeoplasm, but also within a given tumor. Cell shapes include round, plamacytoid and spindled. Nuclei are usually single but bi- and multinucleation may occur, at times frequently. Nuclei tend to be round with disticntly granular chromatin which stains with different intensities; nucleoli are generally inconspicuous. Nuclear diameter may vary tremendously but usually remains smooth and round. Cytoplasm is moderate in volume most often, and, with the MGG stain, is characteristically basophilic with minute red granules.
Lymphoma and lymphoid lesions in the mediastinum (see Chapter 5)
The mediastinum is a characteristic site of presentation of nodular sclerosing Hodgkin lymphoma and sclerosing large cell lymphoma in young women and T-lymphoblastic lymphoma in children and adolescent males. However, all types of non-Hodgkin lymphoma, angiofollicular lymphoid hyperplasia96 and thymoma with a high proportion of lymphocytes enter the differential diagnosis. Thymic hyperplasia in children and adults may also provide problems,97 but can sometimes be suggested on FNB.76,98 Small cell anaplastic carcinoma in the mediastinum may be cytologically difficult to distinguish from lymphoma. Flow cytometry and immunohistochemistry are important adjunctive tests.99,100 Using a combination of cytomorphology, flow cytometry and molecular/genetic analysis, even rare lymphoma variants may be specifically diagnosed at times.39,101
Refer to Chapter 5 for detailed discussion and illustration of lymphoid lesions.
Hodgkin lymphoma38,39,98,102
In the past, cytological findings alone may have been used as a basis for management in primary mediastinal Hodgkin lymphoma. However, it is now widely accepted that minimum diagnostic criteria include a consistent immunocytochemical profile. Table 9.1 includes a simplified summary of results in Hodgkin and non-Hodgkin lymphomas, with antibodies in routine use in the cytology laboratory. Cell blocks, thin cores or smears and cytocentrifuge preparations may all give good results (see also Chapter 5).
Fibrotic Hodgkin’s disease may provide difficulties in obtaining diagnostic material by FNB.
Large cell non-Hodgkin lymphoma may have very similar cytological and histological findings to Hodgkin’s disease, including accompanying fibrosis, an associated reactive lymphoid cell population and multinucleate cells resembling Reed-Sternberg cells. There are also cases with considerable overlap in their immunocytochemical profile and even molecular analysis may not solve the problem. Compared to various small cell lymphomas, large cell forms are often composed of more delicate cells which do not survive flow cytometry as well.
Distinction from anaplastic carcinoma and melanoma can generally be achieved with immunocytochemistry. Reed-Sternberg cells may have less cytoplasm compared to carcinomas and melanomas. The presence of eosinophilic leukocytes in the background may also be a clue to Hodgkin lymphoma.
Hodgkin lymphoma in the mediastinum may be associated with multilocular cystic change in the thymus, with a rim of neoplastic tissue which may not be sampled by the needle, resulting in a false-negative result.1-3
Lymphoblastic lymphoma103-105
We find Papanicolaou staining essential to recognize lymphocyte subtypes; MGG staining is also routinely performed, but in our experience does not allow as close a correlation with histological appearances. The variation induced by air-drying sometimes makes it more difficult to appreciate subtle size differences, to compare cells to small lymphocytes and to examine chromatin pattern. Nevertheless, the two stains are complementary.
In the proper clinical setting, the cellular monotony and high mitotic rate may be the first clue to the diagnosis, especially if material is not optimal and nuclear morphology is compromised.
Flow cytometry is technically easier than immunocytochemistry for most laboratories; we select this ancillary method if the diagnosis is suspected at the time of initial examination of smears in radiology. Flow cytometry cannot show monoclonality for T-lymphoblastic tumors, but may show loss of one or more expected T-cell antigens; identification of rearrangements in T-receptor genes will provide this proof. Cytospins are useful for TdT studies, but this can also be assayed by flow cytometry.
There is a risk of misinterpreting the neoplastic cells as small lymphocytes, especially if preservation is not optimal. In addition, the presence of tingible body macrophages may lure one into considering the changes as reactive hyperplasia. The lymphoid cells in thymomas often have a similar immunophenotype to lymphoblastic lymphoma.65 As stated above, however, a ‘maturing phenotype’ is typical of thymoma, whereas there may be deletions of expected T-cell antigens in lymphoblastic lymphoma.
Large cell lymphoma (± sclerosis) (Fig 9.9)106


Fig. 9.9 Mediastinal large B-cell lymphoma
(A) Dispersed malignant cells with large pleomorphic multilobated nuclei and variable amounts of dense cytoplasm. (H&E, HP); (B) Cell block, intense membrane staining for CD20 (IPOX, HP).
Criteria for diagnosis
Figure 9.9 shows material from a 10-cm anterior/superior mass from a 16-year-old male who presented with chest pain. The pathologist examined material in the radiology theater and the initial working diagnosis was large cell lymphoma (Fig. 9.9A). Material was triaged for flow cytometry, smears and cell blocks, and a 20-g core biopsy was also requested and fixed in formalin. The reports on the cytology and histology were prepared in conjunction by the same pathologist. Flow cytometry was non-diagnostic with only 16% of cells identified as lymphoid and no B-cell clonality detected. This situation is quite commonly seen in large cell lymphomas where the neoplastic cells are presumably fragile and disrupted during measurement, and where only robust small lymphoid cells survive the evaluation process. The cell block showed well-preserved tumor cells staining strongly for CD20 (Fig. 9.9B). The thin cores also contained tumor cells infiltrating through fibrous tissue. Immunohistochemistry was performed on cell blocks and cores and there was positive cytoplasmic staining for CD45, and CD30 and nuclear staining for BCL6, but no staining for ALK1, CD10, CD138, cyclin D1, S-100, cytokeratins, PLAAP or CD117. The Ki-67 proliferation index was > 60%. FISH analysis on tissue showed no disruption of BCL6-MBR, MYC, IgH, ALK or EWSR1, and no IgH-BCL2 fusion, IgH-MYC fusion or EWSR1-FL11 fusion was detected. The diagnosis was mediastinal diffuse large B-cell lymphoma, most likely of thymic subtype. Management was based on these results.
Silverman et al. described specimens where the sample was poorly cellular or composed of microtissue fragments containing distorted spindled lymphoma cells secondary to compression by collagen fibers.106
We have seen a case where cohesive fragments were aspirated leading to a misdiagnosis of thymoma based on cytological study alone, emphasizing the value of immunostaining for confirmation of the diagnosis. We are not aware of a similar published example.
Hodgkin lymphoma with a syncytial growth pattern may mimic large cell lymphoma, carcinoma or melanoma.
Other poorly differentiated primary and secondary tumors, including germ cell tumors, must be excluded.
Angiofollicular lymphoid hyperplasia (Castleman disease)96,108
This unusual reactive process is probably impossible to diagnose specifically by FNAC. Deschenes et al.108 found branching capillaries associated with fragments of germinal centers as a constant feature in their cases and in half of the other published case reports, suggesting that these may be useful criteria. However, any lymphoid mass lesion in which a specific diagnosis of lymphoma or thymoma cannot be made should be reaspirated for ancillary testing and/or biopsied or excised for histopathology.
Germ cell neoplasms36,54,109-117 (see Chapter 13)
Germ cell neoplasms of all types occur in the mediastinum and constitute about 20% of primary mediastinal masses.1-3 A strong association between germ cell tumors and Klinefelter’s syndrome and with hematological neoplasia is recorded.1-3 The need to confirm metastatic spread of germ cell neoplasms within the thorax will also confront the pathologist. Primary germinomas virtually only occur in young males; other germ cell malignancies also show striking male predominance. On the other hand, cystic teratoma present equally in young women and men. Elevated serum levels of human chorionic gonadotrophin (beta-HCG) and alpha fetoprotein, together with clinical findings, may virtually establish the diagnosis in nonseminomatous tumors. Sampling difficulties may prevent the accurate typing of mixed tumors. Due to the common therapy for all subtypes of nonseminomatous germ cell tumors (this may not be true if there is a choriocarcinomatous component), there is less need for exhaustive histological subtyping in advanced cases with widespread disease; however, specific subcategorization is aimed for in localized forms. All types of germ cell tumors have been diagnosed by a combination of cytology and ancillary testing. Most lesions are discussed and illustrated in Chapter 13.
Teratoma (mature cystic)110
Mature cystic teratomas of the mediastinum occur mainly in young women, have similar appearances to the counterpart in the ovary (see Chapter 13) and are benign.
In rare cases, only the granulomatous reaction at the edge of neoplasm may be sampled. If there is only a small amount of cohesive squamous epithelium, the significance may not be appreciated until after resection.
Well-differentiated squamous cell carcinoma usually presents with a dispersed population of keratinized cells, in contrast to the cohesion shown by teratoma. More importantly, the nuclei from a benign teratoma differ greatly form that of keratinizing carcinoma.
Teratoma (immature, malignant)
Immature elements may occur in some tumors. Immature neuroepithelial elements often predominate, resembling neuroblastoma. Other tumors such as carcinosarcoma, blastoma, synovial sarcoma, Wilms’ tumor or malignant mesothelioma will enter the differential diagnosis when biphasic lesions are encountered.
Germinoma
The cytological appearances are identical to seminoma or germinoma elsewhere. The cells are fragile and this results in a so-called ‘tigroid’ background in Romanowsky stains, described also as frothy, bubbly, lace-like or granular, resulting from disrupted cytoplasm with alternating nonglycogenic and glycogenic areas. This pattern can be seen in other glycogen-rich tumors such as embryonal rhabdomyosarcoma118 and fetal adenocarcinoma.119 The pale cytoplasmic crescents and vacuoles seen in MGG-stained intact cells represent glycogen lakes. The nuclei are vesicular with thick membranes and nucleoli. Granulomas and lymphocytic infiltration are variable. This combination can be instantly recognizable, but traumatization of cells or minimal material makes diagnosis a challenge in some instances.
The immunocytochemical profile of germinoma is listed in Table 9.1. Strong diffuse cytoplasmic PLAAP positivity, high glycogen content, absent or minimal focal keratin staining and absent LCA staining are the most useful features.
Large cell/immunoblastic/anaplastic lymphoma may resemble germinoma. The presence of abundant lymphoglandular bodies is strongly suggestive of lymphoma, whereas a tigroid background is not seen in lymphomas. The preservation of true intercellular cohesion and relatively numerous small lymphocytes point to germinoma.
Cell aggregation does occur in germinoma so that it may resemble carcinomas more closely, and when there is moderate pleomorphism, distinction from embryonal carcinoma, yolk sac tumor and anaplastic carcinoma may be difficult. Embryonal carcinoma will often present in three-dimensional aggregates including papillae and lumen formation, which are not expected in germinoma. In addition, N:C ratios tend to be higher. In yolk sac tumor, the neoplastic cells are smaller and usually possess less promient nucleoli than in germinoma and may be associated with hyaline globules and dense matrix material. Specific diagnosis usually requires ancillary testing.
Germinoma in the mediastinum may be largely cystic with minimal tumor tissue in the wall.115
Tumor necrosis may be almost complete; however, the monotonous appearance of the ghost outlines of tumor cells may suggest the diagnosis.120
Embryonal carcinoma109,112-117
In extragonadal cases, the patients are usually young men and the initial cytological impression is one of an anaplastic epithelial tumor, poorly differentiated adenocarcinoma or even squamous cell carcinoma. In this setting a high index of suspicion for the diagnosis allows serum marker testing and a strongly positive result allows diagnosis without further ancillary testing on tissue. If marker levels are minimally elevated the diagnosis is more problematic, because some carcinomas will secrete beta-HCG and alpha fetoprotein; the clinical background may determine management in these cases.
The immunophenotype of embryonal carcinoma is shown in Table 9.1. Strongly positive diffuse staining for cytokeratins and PLAAP, plus Leu-M1 (CD15) and CD30 positivity will be most helpful. Polyclonal PLAAP cross-reacts with the intestinal alkaline phosphatase in some carcinomas.113
Distinction between embryonal carcinoma and the other malignant germ cell neoplasms may be difficult. The cytomorphology may also be very difficult to distinguish from poorly differentiated carcinoma which has spread to the mediastinum, most often from the lung.101
Other germ cell tumors
Pure endodermal sinus (yolk sac) tumor is rare in the mediastinum;54,117 it presents as loosely cohesive epithelial-like cells with mild pleomorphism, rounded nuclei with small nucleoli and vacuolated cytoplasm in a mucoid background. Two forms of vacuolation may be recognized, one due to glycogen (large vacuoles) and the other of uncertain nature. Globular PAS/D-positive intracytoplasmic bodies representing alpha-1 antitrypsin, alpha fetoprotein or laminin may be seen in some cases.54 They are not, however, specific for this tumor type. A background of extracellular basement membrane-like material may also often be present, and is most easily seen as metachromatic material in MGG preparations; with the Papanicolaou stain it has a pale green hue.111 This may be the most important clue to the diagnosis in some cases. A fibrillar background may also be observed.111 The cytological findings may be rather nondescript in some cases, particularly if Papanicolaou stained, but in cell blocks the characteristic reticular or lace-like growth with prominent vessels may be more easily observed. There are numerous histological variants, including a spindle cell form, and these have not been well characterized cytologically.121 The immunocytochemical profile includes strong alpha fetoprotein and PLAAP positivity and cytokeratin positivity.54 High serum levels of alpha fetoprotein can be confirmatory.
Choriocarcinoma109,122 is an extremely rare neoplasm in the mediastinum and distinction from anaplastic carcinoma or other germ cell tumors may be difficult, although serum markers showing very high beta-HCG will be valuable. Sheets of cells representing cytotrophoblast and a giant cell component with multiple obviously malignant nuclei representing syncytiotrophoblast can be seen either lying free or associated with the sheets. Hemorrhage and necrotic debris are characteristic.
Cystic lesions of the mediastinum21,25,51,123-126
It is sometimes possible to suggest the nature of a cyst in the mediastinum based on FNB and imaging. In pericardial cysts, the location and injection of radiopaque dye into the lesion which outlines a thin, smooth cyst wall helps make this diagnosis. We found that the cytological findings in cases of presumed pericardial cyst were inconclusive: no mesothelial cells could be identified; macrophages were the main cellular element along with some lymphocytes. Benign neoplasms and some malignant mediastinal lesions may present as largely cystic structures. Developmental or degenerative thymic or parathyroid cysts may be extremely large and contain lymphocytes and macrophages only. Cystic thymomas may resemble non-neoplastic cysts, until sectioning of their wall reveals small areas of residual neoplasm. Hodgkin lymphoma in young women, germinoma in young men115 and teratoma may all be largely cystic, the neoplastic element forming only a small part of the cyst or in association with multilocular squamous-cystic change in the thymus. This is a non-specific reaction to various disease processes,124 including AIDS125 and various neoplasms including low-grade lymphoma. Bronchogenic or gastroenteric cysts are also well described in this site.123 CT criteria for diagnosing benign cysts include a smooth oval mass with thin walls, homogeneous CT attenuation, near water density, no vascular enhancement or infiltration of nearby mediastinal structures. These, when combined with cytological findings, may allow conservative management in selected cases.123 Atypical fibroblastic cells in cysts have been reported as mimicking malignancy in this site.126
Thyroid lesions
Large retrosternal or ectopic mediastinal multinodular goiters may present as superior mediastinal masses. The diagnosis is easily made if colloid and benign thyroid epithelial cells are recognised. This is not as easy without MGG preparations and may be a source of error,20,25 leading to suspicion of neoplasm. Ectopic anterior mediastinal thyroid can also give rise to neoplasms including Hurthle cell tumors.127,128
Parathyroid lesions
Parathyroid neoplasms are occasionally sampled by FNB. The cytomorphology consists of a monotous pattern of bland cells with round dark nuclei in loose flat clusters and lying singly. Within aggregates, the cells are uniformly distributed, at times with well-defined cell membranes. Immunohistochemistry on accompanying cell blocks or thin core samples manifest chromogranin and parathormone positivity. In adenomas, one expects a very low proportion of Ki-67 positive nuclei but distinguishing an adenoma from an adenocarcioma may be exceedingly difficult. Vu et al. remind us that aspirate assay for parathormone may be very useful, especially if cell-block parathormone immunocytochemistry is not available.129 It has been suggested that aspiration may be useful for parathyroid cysts of this site,130 although there may be some difficulties in interpreting atypical reactive fibroblastic cells in the walls of the cyst.126
Other neoplasms
The most common sarcomas of this site include malignant fibrous histiocytoma and liposarcoma.131,132 Synovial sarcoma is well described.133 We have seen a single case of monophasic synovial sarcoma of mediastinum diagnosed on transoesophageal EUS FNB by the demonstration of SYT-SSX fusion transcripts by FISH on cell blocks, indicating X:18 translocation (all material shown here is courtesy of Dr. Anita Soma, PathWest QE II AP). (Fig. 9.10) The patient was a 45-year-old male with an 11-cm mass adjacent to the lower oesophagus, displacing the heart. Smears showed a rather bland spindle cell population but with mitotic activity. The cell block immunohistochemistry was negative for cytokeratins, CD117 and smooth muscle markers, making leiomyosarcoma and GIST unlikely. The tumor did show positive staining for CD99, BCL2 and CD34, raising the possibility of solitary fibrous tumor or synovial sarcoma. An SYT-SSX1 fusion transcript was detected by reverse transcriptase PCR, reinforcing the FISH cytogenetics. No other diagnostic procedures were undertaken (Fig 9.10).







(A) Large infiltrative mass posterior to heart (Thoracic CT); (B) Loose fascicle of spindle cells including small blood vessels. Background of bare tumor nuclei (H&E, LP); (C) Loose cluster of bland spindle cells but with mitotic activity (H&E, HP); (D) Cell block, small spindle tumor cells with non-specific features (H&E, HP);(E) FISH on cell block, breakapart probe for SYT showing positive disruption of red-green-yellow components (FISH, HP); (F) FISH on cell block, fusion probe for SSX2 (green) and SYT (red) probes showing positive fusion of green and red components. (FISH, HP); (G) FISH on cell block, fusion probe for SSX2 (green) and SYT (red) probes showing positive fusion of green and red components (FISH, HP).
Rhabdomyosarcoma should be considered in the differential diagnosis of small round cell tumors, particularly in children.118 Thymolipoma has been diagnosed cytologically.134
Extramedullary hematopoiesis (EMH)
Rarely, deposits of EMH can present as a mediastinal mass and this entity should be considered when assessing lymphoreticular lesions.135
1 Shimasato Y, Mukai K, Matsuno Y. Tumours of the mediastinum. AFIP Atlas of Tumor Pathology 4th Series, Fascicle 11, American Registry of Pathology and Armed Forces Institute of Pathology, Washington DC. 2010.
2 Travis WD, Brambilla E, Muller-Hermelink HK, Harris CC, editors. Tumours of the lung, pleura, thymus and heart. Pathology and Genetics. World Health Organisation Histological Classification of Tumours. Lyon: IARC Press, 2004.
3 Rosai J. Mediastinum, 9th ed. Rosai J, editor. Akerman’s surgical pathology, vol 1. Mosby, New York, 2004.
4 Morrissey B, Adams H, Gibbs AR, Crane MD. Percutaneous needle biopsy of the mediastinum: review of 94 procedures. Thorax. 1993;48:632-637.
5 Bocking A, Klose KC, Hauptmann S. Cytologic versus histologic evaluation of needle biopsy of the lung, hilum and mediastinum. Sensitivity, specificity and typing accuracy. Acta Cytol. 1995;39:463-471.
6 Medford AR, et al. Mediastinal staging procedures in lung cancer: EBUS, TBNA and mediastinoscopy. Curr Opin Pulm Med. 2009;15:334-342.
7 Fritscher-Ravens A, Davidson BL, Hauber HP, et al. Endoscopic ultrasound, positron emission tomography, and computerized tomography for lung cancer. Am J Respir Crit Care Med. 2003;168:1293-1297.
8 Herth FJ, Becker HD, Ernst A. Ultrasound-guided transbronchial needle aspiration: an experience with 242 patients. Chest. 2003;123:604-607.
9 Krasnik M, Vilmann P, Larsen SS, Jacobsen GK. Preliminary experience with a new method of endoscopic transbronchial real time ultrasound guided biopsy for diagnosis of mediastinal and hilar lesions. Thorax. 2003;58:1083-1086.
10 Kramer H, Sanders J, Post WJ, et al. Analysis of cytological specimens from mediastinal lesions obtained by endoscopic ultrasound-guided fine-needle aspiration. Cancer. 2006;108:206-211.
11 Harbaum L, et al. False-positive mediastinal lymph node cytology due to translesional endocopic ultrasound-guided fine-needle aspirtation in a patient with Barrett’s early cancer. Endoscopy. 2009;41:160-161.
12 Eltoum IA, Chen VK, Chhieng DC, et al. Probabilistic reporting of EUS-FNA cytology: Toward improved communication and better clinical decisions. Cancer. 2006;108:93-101.
13 Khan J, Akhtar M, von Sinner WN, et al. CT-guided fine-needle biopsy in the diagnosis of mediastinal tuberculosis. Chest. 1994;106:1329-1332.
14 Tambouret R, Geisinger KR, Powers CN, et al. The clinical application and cost analysis of fine-needle aspiration biopsy n the diagnosis of mass lesions in sarcoidosis. Chest. 2000;117:1004-1011.
15 Jereb M, Us-Krasovec M. Transthoracic needle biopsy of mediastinal and hilar lesions. Cancer. 1977;40:1354-1357.
16 Adler O, Rosenberger A. Invasive radiology in the diagnosis of mediastinal masses. Use of fine needle for aspiration biopsy. Radiology. 1979;19:169-172.
17 Adler OB, Rosenberger A, Peleg H. Fine needle aspiration biopsy of mediastinal masses: evaluation of 136 experiences. Am J Roentgenol. 1983;140:393-396.
18 Sterrett GF, Whitaker D, Shilkin KB, Walters MN-I. Fine needle aspiration cytology of mediastinal lesions. Cancer. 1983;51:127-135.
19 Weisbrod GL, Lyons DJ, Tao L-C, Chamberlain DW. Percutaneous fine needle aspiration biopsy of mediastinal lesions. Am J Roentgenol. 1984;143:525-529.
20 Bartholdy NJ, Andersen MJ, Thommesen P. Clinical value of percutaneous fine needle aspiration biopsy of mediastinal masses. Analysis of 132 cases. Scand J Thorac Cardiovasc Surg. 1984;18:81-83.
21 Linder J, Olsen GA, Johnston WW. Fine needle aspiration biopsy of the mediastinum. Am J Med. 1986;81:1005-1008.
22 Weisbrod GL. Percutaneous fine needle aspiration biopsy of the mediastinum. Clin Chest Med. 1987;8:27-41.
23 Herman SJ, Holub RV, Weisbrod GL, Chamberlain DW. Anterior mediastinal masses: utility of transthoracic needle biopsy. Radiology. 1991;180:167-170.
24 Wiersama MJ, Kochman ML, Cramer HM, Wiersama LM. Preoperative staging of non-small cell lung cancer: transesophageal US-guided fine-needle aspiration biopsy of mediastinal lymph nodes. Radiology. 1994;190:239-242.
25 Powers CN, Silverman JF, Geisinger KR, Frable J. Fine needle aspiration biopsy of the mediastinum: a multi-institutional analysis. Am J Clin Pathol. 1996;105:168-173.
26 Suen K, Quenville N. Fine needle aspiration cytology of uncommon thoracic lesions. Am J Clin Pathol. 1981;75:803-809.
27 Pak HY, Yokota SB, Friedberg HA. Thymoma diagnosed by transthoracic fine needle aspiration. Acta Cytol. 1982;26:210-216.
28 Sajjid SM, Lukeman JM, Llamas L, Fernandez T. Needle biopsy diagnosis of thymoma. Acta Cytol. 1982;26:503-506.
29 Dahlgren S, Sandstedt B, Sunstrom C. Fine needle aspiration cytology of thymic tumors. Acta Cytol. 1983;27:1-6.
30 Tao L-C, Griffith Pearson F, Coper JD, et al. Cytopathology of thymoma. Acta Cytol. 1984;28:165-170.
31 Miller J, Allen R, Wakefield JSL. Diagnosis of thymoma by fine needle aspiration cytology: light and electron microscopic study of a case. Diagn Cytopathol. 1987;3:166-169.
32 Sherman ME, Black-Schaffer S. Diagnosis of thymoma by needle biopsy. Acta Cytol. 1990;34:63-68.
33 Pinto MM, Dovgan D, Kaye AD, Chinniah A. Fine needle aspiration for diagnosing a thymoma producing CA-125. A case report. Acta Cytol. 1993;37:929-932.
34 Ali SZ, Erozan YS. Thymoma. Cytopathologic features and differential diagnosis on fine needle aspiration. Acta Cytol. 1998;42:845-854.
35 Shin HJ, Katz RL. Thymic neoplasia as represented by fine needle aspiration biopsy of anterior mediastinal masses. A practical approach to the differential diagnosis. Acta Cytol. 1998;42:855-864.
36 Akhtar M, Al Dayel F. Is it feasible to diagnose germ cell tumours by fine needle aspiration biopsy? Diagn Cytopathol. 1997;16:72-77.
37 Moreland WS, Geisinger KR. Utility and outcomes of fine-needle aspiration biopsy in Hodgkin’s disease. Diagn Cytopathol. 2002;26:278-282.
38 Geisinger KR, Lewis Z. Fine needle aspiration of lymph nodes: pattern recognition. In: Zarka M, editor. Practical Cytopathology. Elsevier Press; in press
39 Singh HK, Silverman JF, Powers CN, et al. Diagnosis pitfalls in fine-needle aspiration biopsy of the mediastinum. Diagn Cytopathol. 1997;17:121-126.
40 Assaad MW, Pantanowitz L, Otis CN. Diagnostic accuracy of image-guided percutaneous fine needle aspiration biopsy of the mediastinum. Diagn Cytopathol. 2007;35:705-709.
41 Geisinger KR. Differential diagnostic considerations and potential pitfalls in fine needle aspiration biopsies of the mediastinum. Diagn Cytopathol. 1995;13:436-442.
42 von Bartheld MB, van Kralingen KW, et al. Mediastinal-esophageal fistulae after EUS-FNA of tuberculosis of the mediastinum. Gastrointest Endosc. 2010;71:210-212.
43 Aerts JG, Kloover J, Los J, et al. EUS-FNA of enlarged necrotic lymph nodes may cause infectious mediastinitis. J Thorac Oncol. 2008;3:1191-1193.
44 Doi S, Yasuda I, Iwashita T, et al. Needle tract implantation on the esophageal wall after EUS-guided FNA of metastatic mediastinal lymphadenopathy. Gastrointest Endosc. 2008;67:988-990.
45 Yu C-J, Yang P-C, Chang D-B, et al. Evaluation of ultrasonically guided biopsies of mediastinal masses. Chest. 1991;100:399-405.
46 Van Sonnenberg E, Lin AS, Deutsch AL, Mattrey RF. Percutaneous biopsy of difficult mediastinal, hilar and pulmonary lesions by computed tomographic guidance and modified coaxial technique. Radiology. 1983;148:300-302.
47 Belfiore G, Camera L, Moggio G, et al. Middle mediastinal lesions: preliminary experience with CT-guided fine needle aspiration biopsy with a suprasternal approach. Radiol. 1997;202:870-873.
48 Schenk DA, Bower JH, Bryan L, et al. Transbronchial needle aspiration staging of bronchogenic carcinoma. Am Rev espir Dis. 1986;134:246-248.
49 Roche DH, Wilsher ML, Gurley AM. Transtracheal needle aspiration. Diagn Cytopathol. 1995;12:106-112.
50 Pederson BH, Vilmann P, Folke K, et al. Endoscopic ultrasonography and real-time guided fine needle aspiration biopsy of solid lesions of the mediastinum suspected of malignancy. Chest. 1996;110:539-544.
51 Nath PH, Sanders C, Holley HC, McElvein RB. Percutaneous fine needle aspiration in the diagnosis and management of mediastinal cysts in adults. South Med J. 1988;81:1225-1228.
52 Neill JS, Silverman JF. Electron microscopy of fine needle aspiration biopsies of the mediastinum. Diagn Cytopathol. 1992;8:272-277.
53 Taccagni G, Cantaboni A, dell’Antonio G, et al. Electron microscopy of fine needle aspiration biopsies of mediastinal and paramediastinal lesions. Acta Cytol. 1988;32:868-879.
54 Akhtar M, Ali MA, Sackey K, et al. Fine needle aspiration biopsy diagnosis of endodermal sinus tumor: histologic and ultrastructural correlations. Diagn Cytopathol. 1990;6:184-192.
55 Dennis JL, Vass JK, Wit EC, et al. Identification from public data of molecular markers of adenocarcinoma characteristic of the site of origin. Cancer Res. 2002;62:5999-6005.
56 Buckhaults P, Zhang Z, Chen YC, et al. Identifying tumor of origin using a gene expression-based classification map. Cancer Res. 2003;63:4144-4149.
57 Pavlidis N, Briasoulis E, Hainsworth J, Greco FA. Diagnostic and therapeutic management of cancer of an unknown primary. Eur J Cancer. 2003;39:1990-2005.
58 Baker JJ, Solanki PH, Schenk DA, et al. Transbronchial fine needle aspiration of the mediastinum. Importance of lymphocytes as an indicator of specimen adequacy. Acta Cytol. 1990;34:517-523.
59 Brooks JS. Differential diagnosis of thymic lesions. Acta Cytol. 1999;43:527-529.
60 Hajdu SI. The diagnosis of thymomas. Acta Cytol. 1998;42:843-844.
61 Chhieng DC, Rose D, Ludwig ME, Zakowski MF. Cytology of thymomas: emphasis on morphology and correlation with histologic subtypes. Cancer. 2000;90:24-32.
62 Tao L-C. Lung pleura and mediastinum. In: Kline TS, editor. Guide to clinical aspiration biopsy. New York: Igaku-Skoin, 1988.
63 Wakely PEJr. Cytopathology of thymic epithelial neoplasms. Semin Diagn Pathol. 2005;22:213-222.
64 Fiorella M, Lavin M, Dubey S, Kragel PJ. Malignant thymoma in a patient with HIV positivity: a case report with a review of the differential diagnosis. Diagn Cytopathol. 1997;16:267-269.
65 Friedman HD, Hutchison RE, Kohman LJ, Powers CN. Thymoma mimicking lymphoblastic lymphoma: a pitfall in needle aspiration biopsy interpretation. Diagn Cytopathol. 1996;14:165-171.
66 Dusenbery D. Spindle-cell thymic carcinoid occurring in multiple endocrine neoplasia I: fine needle aspiration findings in a case. Diagn Cytopathol. 1996;15:439-441.
67 Slagel DD, Powers CN, Melaragno MJ, et al. Spindle-cell lesions of the mediastinum: diagnosis by fine-needle aspiration biopsy. Diagn Cytopathol. 1997;17:167-176.
68 Geisinger KR, Woodruff RD, Cappellarri JO. True thymic hyperplasia following cytotoxic chemotherapy: A cause of a false positive aspiration biopsy. Pathol Case Rev. 2001;6:64-67.
69 Riazmontazer N, Bedayat G. Aspiration cytology of an enlarged thymus presenting as a mediastinal mass. A case report. Acta Cytol. 1993;37:427-430.
70 Finley JL, Silverman JF, Strausbauch P, et al. Malignant thymic neoplasms: diagnosis by fine needle aspiration biopsy with histologic, immunocytochemical, and ultrastructural confirmation. Diagn Cytopathol. 1986;2:118-125.
71 Kaw YT, Esparza AR. Fine needle aspiration cytology of primary squamous carcinoma of the thymus. A case report. Acta Cytol. 1993;37:735-739.
72 Riazmontazer N, Beydat C, Izadi B. Epithelial cytologic atypia in a fine needle aspirate of an invasive thymoma. A case report. Acta Cytol. 1992;36:387-390.
73 Posligua L, Ylagan L. Fine-needle aspiration cytology of thymic basaloid carcinoma: case studies and review of the literature. Diagn Cytopathol. 2006;34:358-366.
74 Kapila K, Pathan SK, Amir T, et al. Mucoepidermoid thymic carcinoma: a challenging mediastinal aspirate. Diagn Cytopathol. 2009 Jun;37(6):433-436.
75 Dorfman DM, Shahsafaei A, Chan JKC. Thymic carcinomas, but not thymomas and carcinomas of other sites, show CD5 immunoreactivity. Am J Surg Pathol. 1997;21:936-940.
76 Nonaka D, Henley JD, Chiriboga L, Yee H. Diagnostic utility of thymic epithelial markers CD205 (DEC205) and Foxn1 in thymic epithelial neoplasms. Am J Surg Pathol. 2007;31:1038-1044.
77 Lewis JE, Wick MR, Scheithauer BW, et al. Thymoma. A clinicopathologic review. Cancer. 1987;60:2727-2743.
78 Suster S, Moran CA. Thymoma, atypical thymoma, and thymic carcinoma. A novel conceptual approach to the classification of thymic epithelial neoplasms. Am J Clin Pathol. 1999;111:826-833.
79 Gherardi G, Marveggio C, Placidi A. Neuroendocrine carcinoma of the thymus: aspiration biopsy, immunocytochemistry and clinical correlates. Diagn Cytopathol. 1995;12:158-164.
80 Wang D-Y, Kuo S-H, Chang D-B. Fine needle aspiration cytology of thymic carcinoid tumour. Acta Cytol. 1995;39:423-427.
81 Collins BT, Cramer M. Fine needle aspiration cytology of carcinoid tumours. Acta Cytol. 1996;40:695-707.
82 Nichols CA, Hopkins MB, Geisinger KR. Thymic carcinoid. Report of a case with diagnosis by fine needle aspiration biopsy. Acta Cytol. 1997;41:839-844.
83 Moran CA, Suster S. Neuroendocrine carcinomas (carcinoid tumor) of the thymus. A clinicopathologic analysis of 80 cases. Am J Clin Pathol. 2000;114:100-110.
84 Moran CA, Suster S. Thymic neuroendocrine carcinomas with combined features ranging from well-differentiated (carcinoid) to small cell carcinoma. A clinicopathologic and immunohistochemical study of 11 cases. Am J Clin Pathol. 2000;113:345-350.
85 Suster S, Moran CA. Neuroendocrine neoplasms of the mediastinum. Am J Clin Pathol. 2001;115(Suppl):S17-S27.
86 Smith NL, Finley JL. Lipid-rich carcinoid tumor of the thymus gland: diagnosis by fine-needle aspiration biopsy. Diagn Cytopathol. 2001;25:130-133.
87 Teh BT, Zedenius J, Kytölä S, et al. Thymic carcinoids in multiple endocrine neoplasia type 1. Ann Surg. 1998;228:99-105.
88 Dahl I, Hagmar B, Idvall I. Benign solitary neurilemmoma (Schwannoma). A correlative aspiration cytology and histologic study of 28 cases. Acta Pathol Microbiol Scand (A). 1984;92:91-101.
89 Dahlgren SE, Ovenfors C-O. Aspiration biopsy diagnosis of neurogenous mediastinal tumours. Acta Radiol Diagn (Stockh). 1970;10:408-421.
90 Zbieranowski I, Bedard Y. Fine needle aspiration of Schwannomas. Acta Cytol. 1989;33:381-384.
91 Palombini L, Vetrani A, Veccione R, et al. The cytology of ganglioneuroma on fine needle aspiration smear. Acta Cytol. 1982;26:259-260.
92 Palombini L, Vetrani A. Cytologic diagnosis of ganglioneuroblastoma. Acta Cytol. 1976;20:286-287.
93 Das DK, Pant CS, Rath B, et al. Fine needle aspiration diagnosis of intrathoracic and intra-abdominal lesions: review of experience in the paediatric age group. Diagn Cytopathol. 1993;9:383-393.
94 Silverman JF, Dabbs DJ, Ganick J, et al. Fine needle aspiration cytology of neuroblastoma including peripheral neuroectodermal tumor with immunocytochemical and ultrastructural confirmation. Acta Cytol. 1988;32:367-376.
95 Varma K, Jain S, Mandal S. Cytomorphologic spectrum of paraganglioma. Acta Cytol. 2008;52:549-556.
96 Meyer L, Gibbons D, Ashfaq R, et al. Fine-needle aspiration findings in Castleman’s disease. Diagn Cytopathol. 1999;21:57-60.
97 Bangerter M, Behnisch W, Griesshammer M. Mediastinal masses diagnosed as thymus hyperplasia by fine needle aspiration cytology. Acta Cytol. 2000;44:743-747.
98 Hoerl HD, Wojtowycz M, Gallagher HA, Kurtycz DF. Cytologic diagnosis of true thymic hyperplasia by combined radiologic imaging and aspiration cytology: a case report including flow cytometric analysis. Diagn Cytopathol. 2000;23:417-421.
99 Young NA, Al-Saleem T. Diagnosis of lymphoma by fine-needle aspiration cytology using the revised European-American classification of lymphoid neoplasms. Cancer. 1999;87:325-345.
100 Wakely PEJr. Aspiration cytopathology of malignant lymphoma: coming of age. Cancer. 1999;87:322-324.
101 Yang GC, Yee HT, Wu CD, et al. TIA-1+ cytotoxic large T-cell lymphoma of the mediastinum: case report. Diagn Cytopathol. 2002;26:154-157.
102 Kardos TF, Vinson JH, Behm FG, et al. Hodgkin’s disease: diagnosis by fine needle aspiration biopsy: analysis of cytologic criteria from a selected series. Am J Clin Pathol. 1986;86:286-291.
103 Jacobs JC, Katz RL, Shabb N, et al. Fine needle aspiration of lymphoblastic lymphoma. A multiparameter approach. Acta Cytol. 1992;36:887-893.
104 Kardos TF, Sprague RI, Wakely PEJr, Frable WJ. Fine needle aspiration biopsy of lymphoblastic lymphoma and leukaemia. A clinical, cytologic and immunologic study. Cancer. 1987;60:24-48.
105 Wakely PEJr, Kornstein MJ. Aspiration cytopathology of lymphoblastic lymphoma and leukemia: the MCV experience. Pediatr Pathol Lab Med. 1996;16:243-252.
106 Silverman JF, Raab SS, Park HK. Fine needle aspiration cytology of primary large cell lymphoma of the mediastinum: cytomorphologic findings with potential pitfalls in diagnosis. Diagn Cytopathol. 1993;9:209-215.
107 Francis IM, Das DK, Al-Rubah NAR, Gupta SK. Lymphoglandular bodies in lymphoid lesions and non-lymphoid round cell tumours: a quantitative assessment. Diagn Cytopathol. 1994;11:23-27.
108 Deschênes M, Michel RP, Tabah R, Auger M. Fine-needle aspiration cytology of Castleman disease: case report with review of the literature. Diagn Cytopathol. 2008 Dec;36(12):904-908.
109 Sangali G, Livraghi T, Giosano F, et al. Primary mediastinal embryonal carcinoma and choriocarcinoma. A case report. Acta Cytol. 1986;30:543-546.
110 Harun MH, Yaacob I. Congenital posterior mediastinal teratoma. A case report. Singapore Med J. 1993;34:567-568.
111 Yang GCH. Demonstration of fibrils in the hyaline globules of yolk sac tumor with parietal differentiation in fine needle aspiration smears. Diagn Cytopathol. 1994;10:216-220.
112 Collins KA, Geisinger KR, Wakely PE, et al. Extragonadal germ cell tumours: a fine needle aspiration study. Diagn Cytopathol. 1995;12:223-229.
113 Motoyama T, Yamamoto O, Iwamoto H, Watanabe H. Fine needle aspiration cytology of primary mediastinal germ cell tumors. Acta Cytol. 1995;39:725-732.
114 Chao TY, Nieh S, Huang SH, Lee WH. Cytology of fine needle aspirates of primary extragonadal germ cell tumors. Acta Cytol. 1997;41:497-503.
115 Silverman JF, Olson PR, Dabbs DJ, Landreneau R. Fine-needle aspiration cytology of a mediastinal seminoma associated with multilocular thymic cyst. Diagn Cytopathol. 1999;20:224-228.
116 Chhieng DC, Lin O, Moran CA, et al. Fine-needle aspiration biopsy of nonteratomatous germ cell tumors of the mediastinum. Am J Clin Pathol. 2002;118:418-424.
117 Yang GC, Hwang SJ, Yee HT. Fine-needle aspiration cytology of unusual germ cell tumors of the mediastinum: atypical seminoma and parietal yolk sac tumor. Diagn Cytopathol. 2002;27:69-74.
118 de Almeida M, Stastny JF, Wakely PEJr, Frable WJ. Fine-needle aspiration biopsy of childhood rhabdomyosarcoma: reevaluation of the cytologic criteria for diagnosis. Diagn Cytopathol. 1994;11:231-236.
119 Geisinger KR, Travis WD, Perkins LA, Zakowski MF. Aspiration cytomorphology of fetal adenocarcinoma of the lung. Am J Clin Pathol in press.
120 Dunsmore N, Sherman ME, Erozan YS. Massive necrosis: a pitfall in the cytopathologic diagnosis of primary mediastinal seminoma. Diagn Cytopathol. 1991;7:323-324.
121 Moran CA, Suster S. Yolk sac tumors of the mediastinum with prominent spindle cell features: a clinicopathologic study of three cases. Am J Surg Pathol. 1997;21:1173-1177.
122 Moran CA, Suster S. Primary mediastinal choriocarcinoma: a clinicopathologic and immunohistochemical study of eight cases. Am J Surg Pathol. 1997;21:1007-1012.
123 Kuhlman JE, Fishman EK, Wang KP, et al. Mediastinal cysts: diagnosis by CT and needle aspiration. Am J Roentgenol. 1988;150:75-78.
124 Suster S, Rosai J. Multilocular thymic cyst. An acquired reactive process. Study of 18 cases. Am J Surg Pathol. 1991;15:388-398.
125 Chhieng DC, Demaria S, Yee HT, Yang GC. Multilocular thymic cyst with follicular lymphoid hyperplasia in a male infected with HIV. A case report with fine needle aspiration cytology. Acta Cytol. 1999;43:1119-1123.
126 Marco V, Carrasco MA, Marco C, Bauza A. Cytomorphology of a mediastinal parathyroid cyst. Report of a case mimicking malignancy. Acta Cytol. 1983;27:688-692.
127 Mishriki YY, Lane BP, Lozowski MS, Epstein H. Hurthle-cell tumor arising in the mediastinal ectopic thyroid and diagnosed by fine needle aspiration. Light microscopic and ultrastructural features. Acta Cytol. 1983;27:188-192.
128 De Las Casas LE, Williams HJ, Strausbauch PH, Silverman JF. Hurthle cell adenoma of the mediastinum: intraoperative cytology and differential diagnosis with correlative gross, histology, and ancillary studies. Diagn Cytopathol. 2000;22:16-20.
129 Vu DH, Erickson RA. Endoscopic ultrasound-guided fine-needle aspiration with aspirate assay to diagnose suspected mediastinal parathyroid adenomas. Endocr Pract. 2010;16:437-440.
130 Downey RJ, Cerfolio RJ, Deschamps C, et al. Mediastinal parathyroid cysts. Mayo Clin Proc. 1995;70:946-950.
131 Attal H, Jenson J, Reyes CV. Myxoid liposarcoma of the anterior mediastinum. Diagnosis by fine needle aspiration biopsy. Acta Cytol. 1995;39:511-513.
132 Munjal K, Pancholi V, Rege J, et al. Fine needle aspiration cytology in mediastinal myxoid liposarcoma: a case report. Acta Cytol. 2007;51:456-458.
133 Suster S, Moran CA. Primary synovial sarcomas of the mediastinum: a clinicopathologic, immunohistochemical, and ultrastructural study of 15 cases. Am J Surg Pathol. 2005;29:569-578.
134 Heimann A, Sneige N, Shirkhoda A, DeCaro LF. Fine needle aspiration cytology of thymolipoma. A case report. Acta Cytol. 1987;31:335-339.
135 Al-Marzooq YM, Al-Bahrani AT, Chopra R, Al-Momatten MI. Fine-needle aspiration biopsy diagnosis of intrathoracic extramedullary hematopoiesis presenting as a posterior mediastinal tumor in a patient with sickle-cell disease: case report. Diagn Cytopathol. 2004;30:119-121.